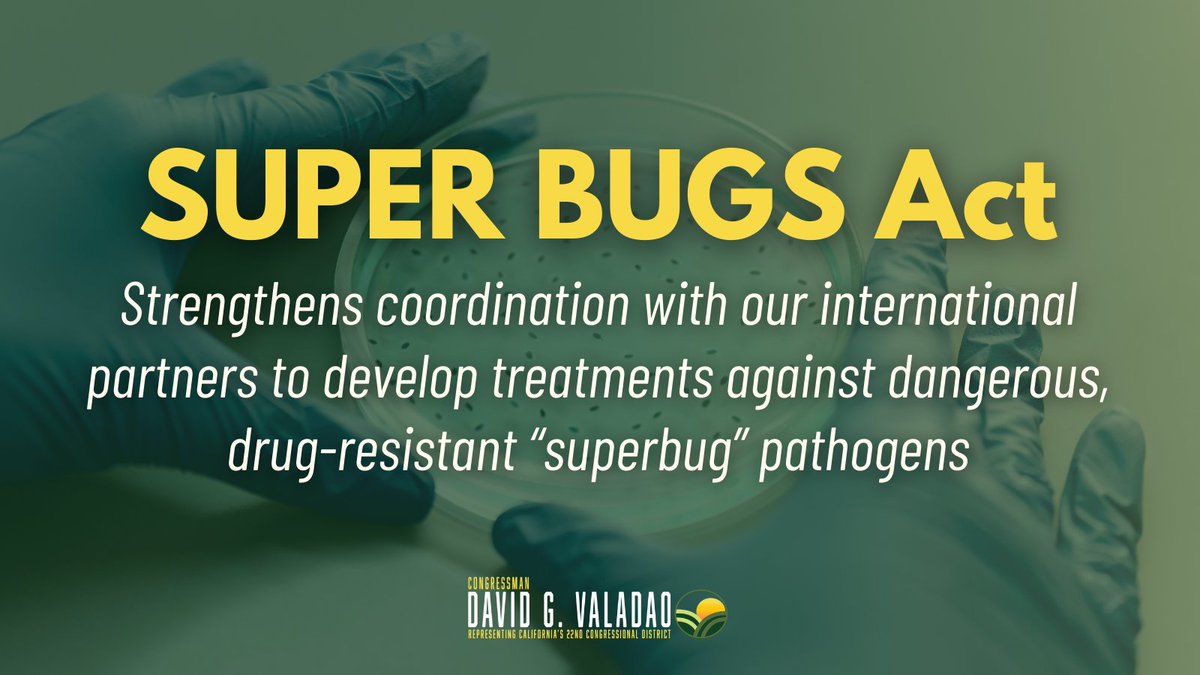
Rep. David Valadao tweet media

Sabitlenmiş Tweet

Want to learn more about my work in Washington on behalf of #CA22? Sign up for my e-newsletter to get weekly updates on my work in Washington directly to your inbox.
Sign up here: valadao.house.gov/forms/emailsig…

English
Rep. David Valadao
3.3K posts

@RepDavidValadao
Proudly Representing California's 22nd Congressional District. Serving the Valley on @HouseAppropsGOP

BREAKING: The FBI has warned police departments in California that Iran wants to retaliate for American attacks by launching offensive drones against the West Coast, according to an alert reviewed by ABC News. abcnews.com/US/fbi-warns-i…










